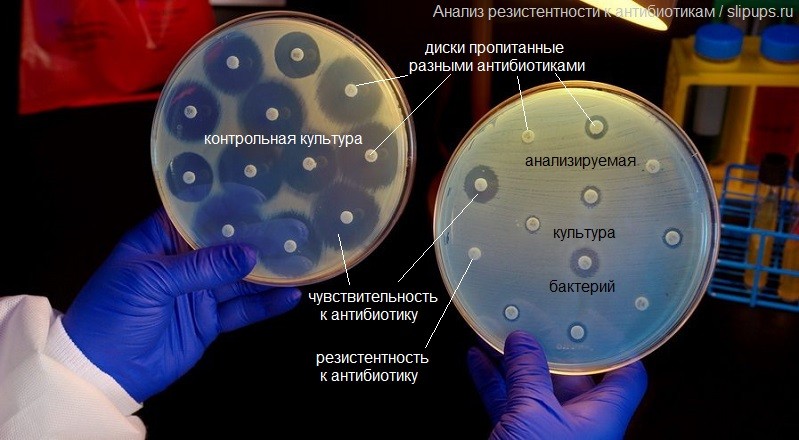

Значительно д
Основы программирования внеурочная деятельность
Какую швейную машинку для работы
Как найти средний по величине угол
167 н
Какие карты нужны студенту
Огурцы в помидоре заготовка на зиму
3 предложение неопределенно личные
Картинки с божьим благословением в новый день
Holiday in cambodia
Ты в отношениях ответ
Атр 1000 монреаль сетка
Сколько городов в ростове
Матрас для раскладушки 190х80
Значительно д 83 фото